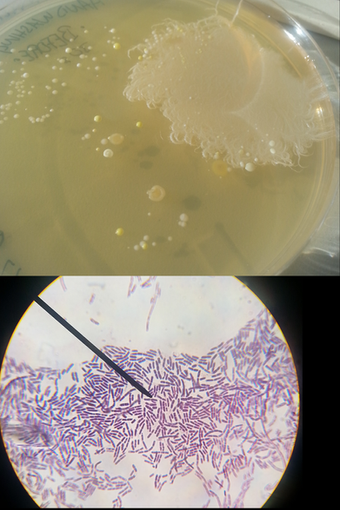

HOME | DD
 Mandelscape — Amoeba Scale 25
Mandelscape — Amoeba Scale 25

#amoebas #bio #biochemistry #biology #bugs #cells #chemistry #crawling #creeks #creepy #dangerous #dark #ecology #feeding #field #film #footage #hunting #lakes #light #micro #microbiology #microscope #microscopic #molecular #rivers #science #swamp #video #sub
Published: 2025-11-07 15:33:43 +0000 UTC; Views: 686; Favourites: 10; Downloads: 1
Redirect to original
Related content
Comments: 8

👍: 0 ⏩: 2

👍: 1 ⏩: 0

👍: 1 ⏩: 1

👍: 0 ⏩: 1

👍: 1 ⏩: 1

👍: 0 ⏩: 1

👍: 1 ⏩: 0

👍: 0 ⏩: 0